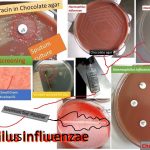
Haemophilus influenzae  colonies on chocolate agar after overnight incubation in a carbon dioxide atmosphere as shown above image. It must contain haemin or other iron-containing porphyrin and nicotinamide adenine dinucleotide  (NAD) or its phosphate (NADP). The porphyrin requirement is referred to as growth factor X and the NAD or NADP requirement as growth factor V. It was causative agent of  the devastating 1918 pandemic of influenza to now from local to systemic infections.

Tag: Antigenic Structures of Haemophilus Influenzae
Immunology Short Notes: Introduction and Related Topics
 Immunology Short Notes 'Immunology Short Notes' makes it easier to...
Immunology Short Notes 'Immunology Short Notes' makes it easier to...
Haemophilus influenzae: Introduction, Morphology, Pathogenecity, Laboratory Diagnosis, Treatment and Key Notes
Introduction of Haemophilus influenzae Haemophilus influenzae colonies on chocolate agar after overnight...
Introduction of Haemophilus influenzae Haemophilus influenzae colonies on chocolate agar after overnight...
